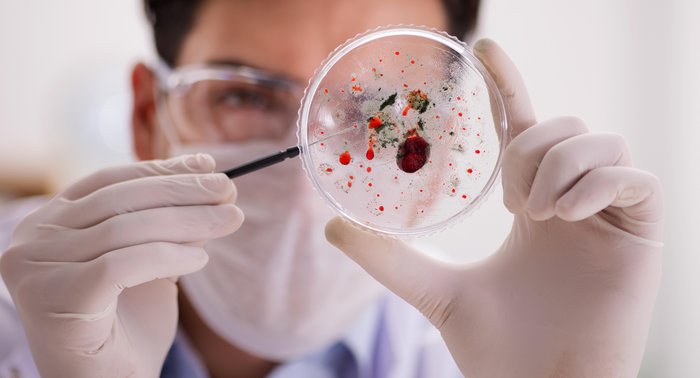
Elnur / stock.adobe.com

Desde que as autoridades sanitárias de Gana confirmaram que foram identificados dois casos de pessoas contaminadas com o vírus de Marburg, a população da região e dos países vizinhos tem se preocupado com a disseminação do agente infeccioso. A doença é altamente contagiosa e pode levar, em casos mais extremos, à morte.
Os dois pacientes que se contaminaram acabaram falecendo um dia após o diagnóstico. O primeiro era um homem de 26 anos que foi internado em 26 de junho. O outro, também do sexo masculino, de 51 anos, que chegou ao hospital em 28 de junho. A confirmação pelas autoridades sanitárias de Gana ocorreu no domingo (17).
Além das mortes, 98 pessoas estão em quarentena com suspeita de contaminação. Apesar de ser a primeira vez que a doença é identificada em Gana, há registros anteriores de surtos em outros países como África do Sul, Quênia, República Democrática do Congo, Uganda e Zimbábue.
Não há tratamento para a doença, porém, os médicos recomendam a ingestão de muita água e buscam tratar os sintomas específicos para elevar as chances de sobrevivência dos pacientes. Uma série de produtos sanguíneos, entre medicamentos e imunoterapia, estão sendo desenvolvidos, segundo a OMS. O sangue é utilizado para reposição em infectados, assim como muitos líquidos.
Para evitar o contágio, as autoridades sanitárias recomendam que as pessoas se mantenham longe de cavernas, ambiente propício à presença de morcegos, e que cozinhem bem os alimentos feitos à base de carne antes de consumi-los. GZH separou uma lista com as principais informações sobre a doença desde sua origem até os sintomas. As informações são da BBC e do jornal O Globo.
O que é?
O vírus de Marburg é considerado um "primo" do Ebola, pois é da mesma família do microrganismo e é tão letal quanto ele.
Ainda não há consenso na comunidade científica sobre como o agente infeccioso surgiu, mas alguns especialistas acreditam que tenha se originado entre macacos verdes africanos que foram importados de Uganda.
Onde ocorreu o primeiro surto?
O primeiro registro do vírus aconteceu em 1967 na cidade alemã de Marburg, que dá nome ao agente infeccioso. Nessa época, a doença se espalhou pelas antigas Alemanha Ocidental e Iugoslávia, causando a infecção de 32 pessoas. Desse total, sete pessoas morreram.
Além desse primeiro surto na Alemanha, outros casos foram registrados nos anos seguintes em países como Angola, África do Sul, Quênia, República Democrática do Congo e Uganda. Segundo dados da Organização Mundial da Saúde (OMS), em muitos casos de surtos, a doença ocasionou a morte de um número considerável de pacientes:
- Alemanha (1967): 29 casos; sete mortes
- República Democrática do Congo (1998-2000): 154 casos; 128 mortes
- Angola (2005): 374 casos; 329 mortes
- Uganda (2012): 15 casos; quatro mortes
- Uganda (2017): três casos; três mortes
Como a doença se espalha?
Segundo a OMS, a doença do vírus de Marburg é transmitida aos seres humanos por morcegos frugívoros e se propaga pelo contágio direto com fluidos corporais de pessoas infectadas, superfícies e manuseio de materiais. Mesmo se a pessoa infectada se recuperar, poderá transmitir a outros indivíduos depois de meses.
Quais são os sintomas?
Inicialmente, o paciente que se infectou com o vírus apresenta os seguintes sintomas:
- Dor de cabeça severa
- Dores musculares
- Febre
Após três dias da contaminação, podem surgir outros sintomas:
- Diarreia aquosa
- Dor de estômago
- Extrema letargia
- Náusea
- Vômito
Em casos mais graves, geralmente associados a oito ou nove dias após a infecção, a pessoa pode apresentar sangramento em várias partes do corpo. A doença também pode levar a óbito.









